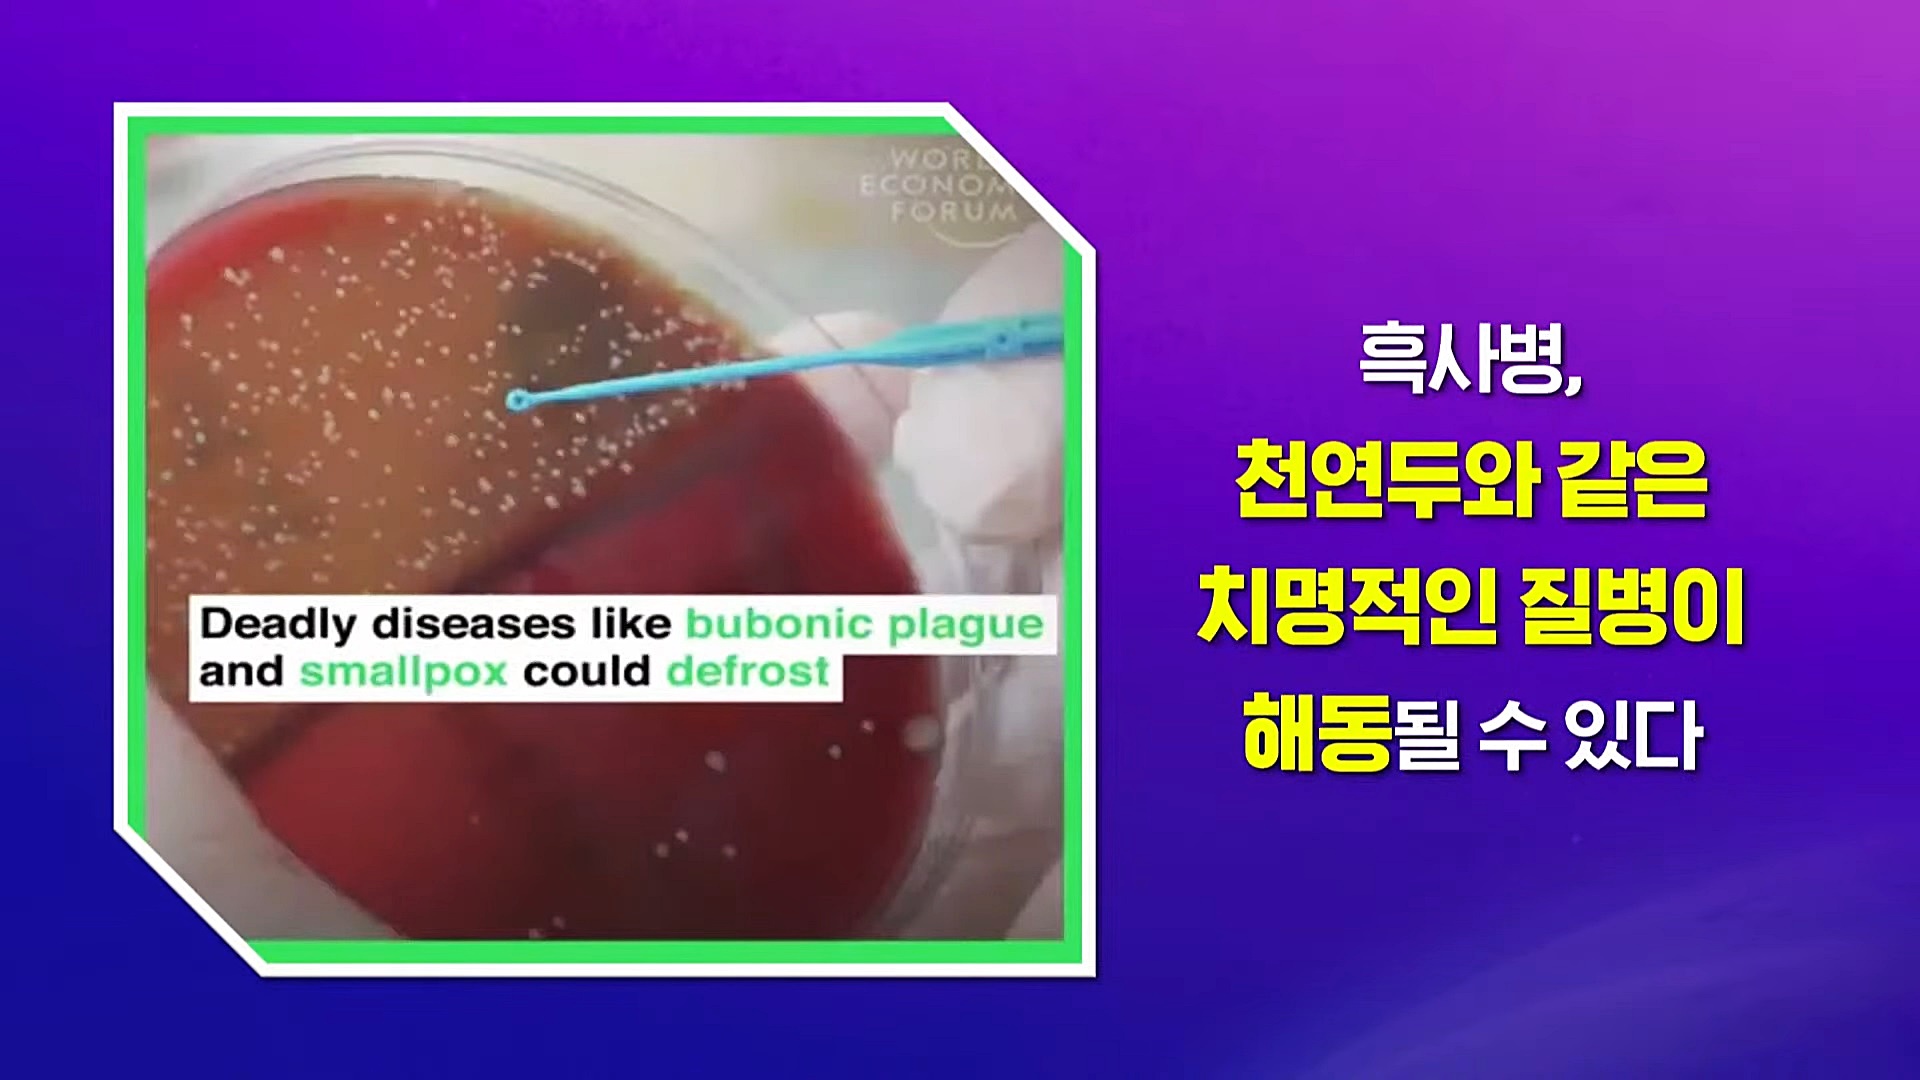

《STB상생개벽뉴스 147, 148, 149회》
주제: 나의 심신(心身)과 영체가 빛으로 채워질 때 천지와 만물과 하나 된다.
내 몸과 마음의 병을 고치는 생활 속의 자가치유 증산도 무병장수 명상수행

3년 넘어선 코로나19 팬데믹 감염자와 사망자는 공식적으로 집계된 것만 약 7억 명과 7백만 명에 이릅니다. 코로나19 팬데믹을 통해 전 세계 인구가 동시에 생명과 건강의 소중함을 더 절실하게 느끼는 계기가 됐습니다. 코로나19 팬데믹을 통해 초연결사회가 된 지구촌은 순식간에 방역과 의료체계가 붕괴한다는 것을 직접 확인했습니다.
2014년 출범한 '글로벌보건안보구상'은 현재 71개 회원국과 세계보건기구(WH0)와 세계동물보건기구(WOAH) 등 10개 국제기구가 참여합니다. 2022년 말 대한민국 수도 서울에서 '글로벌보건안보구상(GHSA) 장관급 회의'가 열렸습니다. '글로벌보건안보구상' 회의에 참석한 방역·의료전문가들은 한목소리로 다음 팬데믹을 대비하기 위해 모두 힘을 모아야 한다고 말했습니다.






10개 국제기구와 회원국 대표들이 감염병 등 인류 공동의 보건안보 위협에 대응 방안을 논의하는 '글로벌보건안보구상(GHSA) 장관급 회의' 행사에서 다가올 '미지의 질병(Disease X)', 곧 다음 팬데믹을 대비하기 위한 모의훈련이 있었다는 사실입니다. 다시 말해 넥스트 팬데믹은 언제 어디서 발생할지 모르지만, 이미 결정되어 있다고 기정사실화한 것입니다.
도기(道紀) 38년(무신, 서력 1908) 가을 천지부모님이신 상제님과 태모님께서 태전(대전)에 오셔서 천지의 조화로 신과 인간이 하나 되어 내 몸과 마음의 병을 고치는 생활 속의 자가치유 명상수행법인 도공(道功)을 전수하는 천지공사를 보셨습니다. 또한, 도기 39년(기유, 1909년 3월) 김형렬 성도님에게 신선(神仙) 도수와 김자현 성도님에게 의원(醫員) 도수를 붙이셨습니다.






인류 태고시대 정통 생활 속의 자가치유 명상수행법을 복원하고 완성한 상제님과 태모님께서 전수하신 도공(道功)과 신선 도수와 의원 도수는 증산도 안경전 종도사님을 통해 후천 삼신조화 신선도통(後天 三神造化 神仙道通) 무병장수 명상수행법으로 공개된 것입니다. 나의 정성과 노력을 바탕으로 천지부모님의 조화 권능과 주문(呪文)의 원력과 도력과 신권을 발동시켜 내 몸과 마음의 병을 고치면서 무병장수의 신선몸으로 바꾸는 큰 은혜를 받는 수행법입니다.
100여 년 전 인간과 신명(神明)이 하나 되어 나아갈 새 역사를 천지에 질정(質定)한 천지부모이신 상제님과 태모님께서 "병(病) 고치는 약(藥)이 귀한 것이 아니요, 병들지 않는 몸이 귀한 것이니 스스로 몸을 잘 지켜 달리 약을 구하지 말라.", "제 오장육부(五臟六腑) 통제(統制) 공부로 제 몸 하나 새롭게 할 줄 알아야 하느니라."라고 말씀하셨습니다. 생활 속의 자가치유 은혜를 받는 증산도 무병장수 명상수행으로 코로나19 팬데믹과 넥스트 팬데믹을 극복하시기를 기원합니다.





《STB상생개벽뉴스 147회》
2023년 1월 18일 방송 - 내 몸과 마음의 병과 어둠을 몰아내는 빛의 몸 만들기
https://www.youtube.com/watch?v=6MYzwwbOJMo
《STB상생개벽뉴스 148회》
2023년 1월 19일 방송 - 우주의 빛의 몸, 신선의 몸 만들기
https://www.youtube.com/watch?v=Kx7Op5EJ5hI
《STB상생개벽뉴스 149회》
2023년 1월 20일 방송 - 빛의 몸 만들기 체험 사례와 수행
https://www.youtube.com/watch?v=01RXvUcc-6g


'동방신선학교, 우주1년' 카테고리의 다른 글
| 제주도 제주시 한라대학교 컨벤션홀 증산도 무병장수 선려화 치유수행 (14) | 2023.02.21 |
|---|---|
| 삶을 질을 저하시키는 코로나 후유증 롱코비드를 자가치유하는 명상수행 (16) | 2023.02.09 |
| 바이러스의 습격 다음 팬데믹 세계적 대유행에서 살아남는 방법 (13) | 2023.02.08 |
| 우리 몸의 질병과 마음의 병과 상처받은 영혼을 소리로 치유하는 힐링사운드 (10) | 2023.02.04 |
| 주문은 우주의 신성한 음악이며 하나님의 소리와 천상의 노래다 (14) | 2023.02.03 |
| 기독교 성경 창세기 장수한 인물과 다가오는 무병장수 초장수 시대 (17) | 2023.02.02 |
| 자연과 하나 되어 소통하고 신과 하나 되어 영성이 충만했던 인류의 황금시대 (15) | 2023.02.01 |
댓글